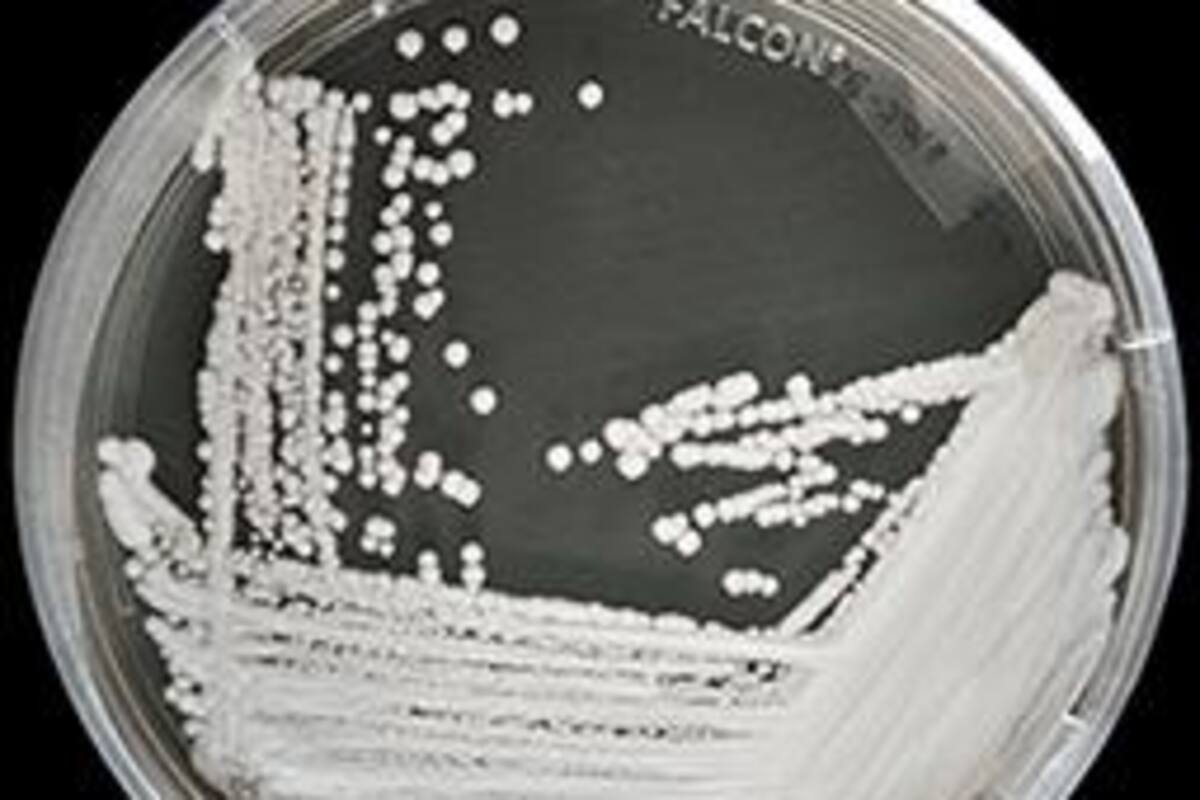
Candida Auris: Lo que debes saber del "Super hongo" resistente a medicamentos

Candida Auris: Lo que debes saber del "Super hongo" resistente a medicamentos
La seriedad de la enfermedad es grave. Uno de cada tres pacientes con C. auris (infecciones en la sangre, cerebro, corazón, etc.) mueren.
CALIFORNIA.-Se ha encontrado un hongo que es resistente a los medicamentos comunes en dos hospitales y un hogar de ancianos de Estados Unidos, revelaron funcionarios de salud.
El hongo fue identificado en un hogar de ancianos en Washington, DC, y dos hospitales en Dallas, Texas, según los Centros para el Control y la Prevención de Enfermedades (CDC).
Los dos brotes incluyeron alrededor de 120 pacientes en total.
De ellos, las infecciones en cinco pacientes fueron resistentes a todos los tipos de medicamentos antimicóticos y tres pacientes murieron.
Este hongo es considerado una 'amenaza grave para la salud global' por los CDC, y la evidencia de estos nuevos brotes muestra que se propaga de persona a persona, no solo a través de tratamientos o superficies hospitalarias, informa Daily Mail.
Formalmente conocido como Candida Auris, el hongo es una forma de levadura que puede ser mortal para los pacientes de hospitales y hogares de ancianos que tienen problemas médicos graves, detalla Fox News.
Esta es realmente la primera vez que comenzamos a ver grupos de resistencia en los que los pacientes parecían contraer infecciones entre sí", indicó la Dra. Meghan Lyman de los CDC.
Los funcionarios de salud han hecho sonar las alarmas durante años sobre el superhongo después de ver infecciones en las que los medicamentos de uso común tuvieron poco efecto.
En 2019, los médicos diagnosticaron tres casos en Nueva York que también eran resistentes a una clase de medicamentos, llamados equinocandinas, que se consideraban una última línea de defensa.
En esos casos, no hubo evidencia de que las infecciones se hubieran propagado de un paciente a otro; los científicos concluyeron la resistencia a los medicamentos formada durante el tratamiento.
¿Qué es Candida auris?
Candida auris es un hongo patogénico que puede ocasionar infecciones y enfermedades serias, predominantemente en pacientes hospitalizados.
¿Cuáles son los síntomas de una enfermedad
causada por C. auris?
C. auris es frecuentemente mal-identificada. Pacientes que padecen de una infección causada por C.auris exhiben síntomas respectivos a la parte del cuerpo afectada, que quiere decir que los síntomas varían de caso a caso.
¿Qué tan seria puede llegar a ser una infección de C. auris?
La seriedad de la enfermedad es grave. Uno de cada tres pacientes con C. auris (infecciones en la sangre, cerebro, corazón, etc.) mueren.
¿Cómo se transmite C. auris?
La gente se puede infectar de diversas maneras:
- Al tocar superficies u objetos contaminados con C. auris
- Al tener contacto directo con una persona infectada
Sigue nuestro canal de WhatsApp
Recibe las noticias más importantes del día. Da click aquí
Grupo Healy © Copyright Impresora y Editorial S.A. de C.V. Todos los derechos reservados